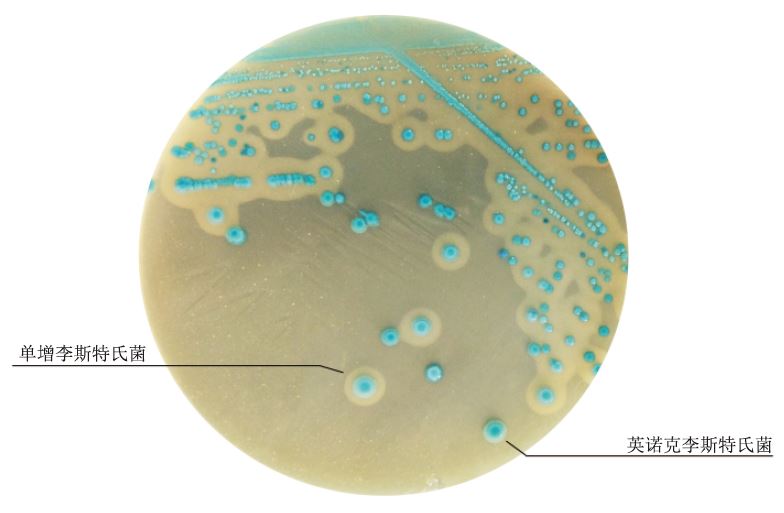

OA李斯特氏菌显色培养基是九州登录网页中国有限公司根据GB4789.30标准生产,用于食品中单增李斯特氏菌的检验。单增李斯特氏菌菌落呈蓝色,周围有一不透明环。
成分(g/L)
基础培养基(g/L)
蛋白胨
|
18.0g
|
硫酸镁
|
0.5g
|
胰蛋白胨
|
6.0g
|
氯化钠
|
5.0g
|
酵母浸粉
|
10.0g
|
氯化锂
|
10.0g
|
丙酮酸钠
|
2.0g
|
磷酸氢二钠
|
2.5g
|
葡萄糖
|
2.0g
|
5-溴-4-氯-3-吲哚-β-D-吡喃葡萄糖苷
|
0.05g
|
甘油磷酸镁
|
1.0g
|
琼脂
|
15g
|
pH7.2±0.2 25℃
|
李斯特氏菌抑菌剂5支
此配方可以进行改良或增加营养成份以获得最佳的结果
操作步骤:
使用前,把制备好的培养基放置室温10-20分钟。
1. 按GB4789.30标准制备样品液;
2. 把样品液加入Fraser增菌肉汤(FB1、FB2)中增菌;或使用PBS或Fraser增菌肉汤(无添加剂)进行稀释;
3. 取一环增菌液划线或涂布法接种到李斯特氏菌显色培养基上,36±1℃培养24-48小时。
质量控制
1.外观
此干燥培养基的粉末均匀,具有良好的流动性,呈淡黄色。制备好的平板呈不透明淡黄色培养基。
2.微生物试验
质控菌株
|
菌株编号
|
生长情况
|
菌落颜色
|
不透明环
|
单核细胞增生李斯特氏菌
|
ATCC 19114
|
+++
|
蓝绿色
|
+
|
英诺克李斯特氏菌
|
ATCC 33090
|
+++
|
蓝绿色
|
-
|
伊氏李斯特氏菌
|
CICC 21663
|
+++
|
蓝绿色
|
+
|
|
斯氏李斯特氏菌
|
CICC 21671
|
+++
|
蓝绿色
|
-
|
金黄色葡萄球菌
|
ATCC 25923
|
-
|
-
|
-
|
大肠埃希氏菌
|
ATCC 25922
|
-
|
-
|
-
|
鼠伤寒沙门氏菌
|
ATCC 14028
|
-
|
-
|
-
|
黑曲霉
|
ATCC 16404
|
-
|
-
|
-
|
典型特征
单增李斯特氏菌36℃±1℃培养24-48小时,平板上出现蓝色菌落,菌落周围有一不透明环。伊氏李斯特氏菌36℃±1℃培养48小时,平板上出现蓝色菌落,菌落周围有一不透明环。英诺克李斯特氏菌36℃±1℃培养24-48小时,平板上出现蓝色菌落,菌落周围没有不透明环。在食品检测中伊氏李斯特氏菌非常少见。
贮存
制备好的固体平板保存于2-8℃,应避免光线直接照射。干燥培养基应放置干阴暗干处,保存温度2-8℃。
失效
干燥培养基超过保质期、结块和颜色变化都不能使用。
注意
此培养基仅供实验室使用。
OA李斯特氏菌显色平板(9cm)(GB4789.30-2025单李标准)微生物灵敏度试验:
接种以下质控菌株,放置36±1℃需氧培养24-48小时。

相关资料:
李斯特氏菌的初步检测 点击查看
李斯特氏菌显色平板的制备 点击查看
李斯特氏菌显色培养基原理和使用方法 点击查看


 海博微信公众号
海博微信公众号
 海博天猫旗舰店
海博天猫旗舰店


 海博微信公众号
海博微信公众号
 海博天猫旗舰店
海博天猫旗舰店






